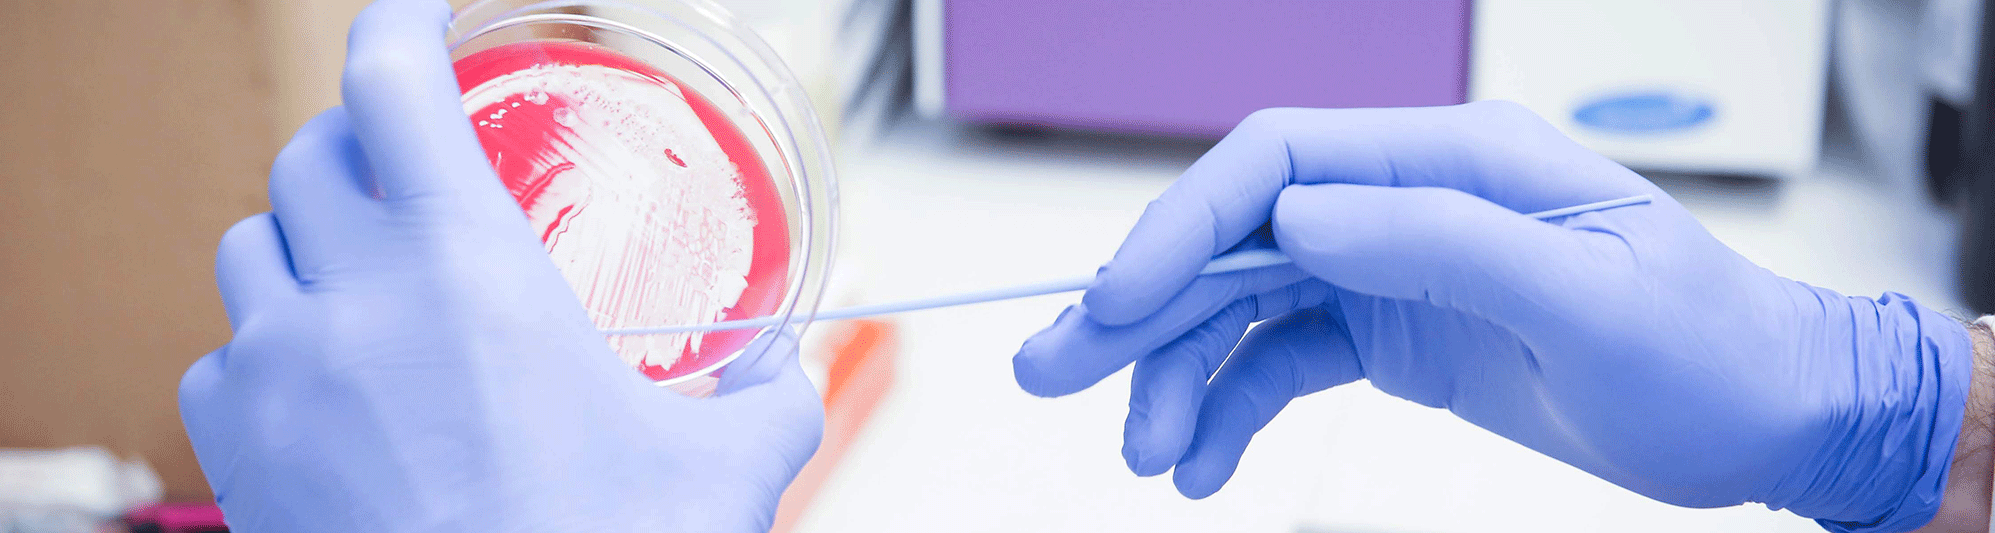

The ARLG Laboratory Center manages a biorepository of clinical study isolates and well-characterized gram-positive and gram-negative bacterial isolates. Investigators can access bacterial isolate strains from published manuscripts to develop diagnostic tests and novel antimicrobial compounds and to conduct studies evaluating mechanisms of resistance.
The Laboratory Center supports the ARLG research agenda by leading the development, implementation, and evaluation of the laboratory research (see Antibacterial Resistance Leadership Group 2.0 - Back to Business CID, 15 Aug 2021, PMID: 33588438, and https://doi.org/10.1093/cid/ciab141 ).
Biorepository Strain Catalogue
The ARLG Biorepository Strain Catalogue is a web-based system to help investigators review available isolate strains. ARLG will provide up to 80 strains per year for each laboratory or company. Requests for a larger number of isolates or isolates that are not yet published by the ARLG will require approval from the Laboratory Center Director.
You may review available strains by visiting the Biorepository Strain Catalogue.
To request isolates (strains), please apply using the ARLG Interest Survey.
Assistance with Questions
The ARLG Lab Center Frequently Asked Questions (FAQ) page and the Biorepository Visitor Quick Reference Guide can provide additional information to help you:
- Access the catalogue
- Search and review strains
- Develop a wish list of strains
- Request strains
If you have additional questions, please email the ARLG Lab Center Operations team at ARLG-Lab-Center-Operations@dm.duke.edu.
Isolates Available from Other Resources
BEI Resources was established by the National Institute of Allergy and Infectious Diseases (NIAID) to provide reagents, tools and information for studying Category A, B, and C priority pathogens, emerging infectious disease agents, non-pathogenic microbes and other microbiological materials of relevance to the research community.
The CDC AR Isolate Bank is a centralized repository of microbial pathogens with well-characterized resistance profiles that are assembled by the Centers for Disease Control and Prevention (CDC) in collaboration with the Food and Drug Administration (FDA).
The Multidrug-resistant Organism Repository and Surveillance Network (MRSN) is a department within the Walter Reed Army Institute of Research (WRAIR) made up of a microbiology laboratory, organism repository, and a seven-facility network of Army hospitals including those in combat zones. Isolates are preserved and characterized, and are distributed through Army Public Health Command venues. The network is currently targeting methicillin-resistant Staphylococcus aureus (MRSA), and multidrug-resistant Escherichia coli, Klebsiella pneumoniae, Pseudomonas aeruginosa, and Acinetobacter baumannii.